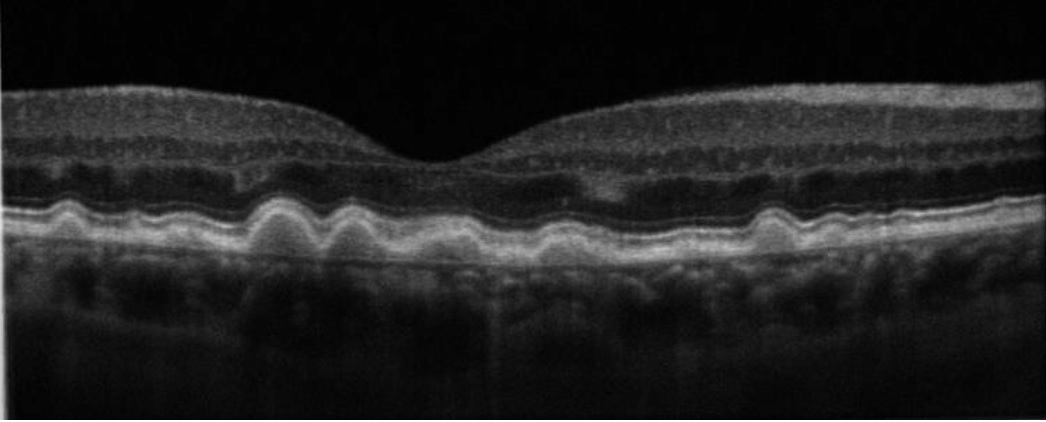

Quais são as principais características epidemiológicas da DMRI?
Quais são os principais genes relacionados com a DMRI?
Gene CFH
Gene ARMS 2
Quais são os tipo de DMRI e qual é o tipo que está mais relacionado a cegueira?
DMRI Seca (90% dos casos de DMRI)
* 20% dos casos de cegueira por DMRI
DMRI Úmida (10% dos casos de DMRI)
*80% dos casos de cegueira por DMRI
Quais são os achados característicos da DMRI seca?

O que são Drusas?
Excrescências do EPR
Material Hialino rico em lipídios, que se acumulam entre o EPR e a Membrana de Bruch em pacientes com predisposição, ao longo dos anos.

Como podemos classificar as drusas?
Drusas Duras
Drusas Moles
* se associada com alteração pigmentar (50%)

Como podemos classificar as drusas, segundo o seu tamanho?
Pequenas: <63 micrômetros
Médias: 63-125 micrômetros
Grandes: > 125 micrômetros
*** A Veia Central da Retina, na sua emergência no DO, tem 125 micrômetros de diâmetro, o que nos permite comparar com ela, as drusas, e assim determinar se são Grandes ou não.
O que é o DEP Drusenoide?
DEP Drusenoide ocorre quando temos a confluência de drusas moles, levando à um descolamento do EPR > 1000 micrômetro (CBO) OU > 350 micrômetros (AAO).
Qual é a fisiopatologia da DMRI?
Os depósitos de materias entre o EPR e a Membrana de Bruch (drusas) criam uma barreira que dificultam a as trocas realizadas entre coriocapilar, EPR e Fotorreceptores e gera sofrimento do EPR. A falta de Fatores Tróficos produzidos pelo EPR lesam a coriocapilar, que deixa de nutrir os fotorreceptores, gerando atrofia local.
Quais são os achados característicos da AGF na DMRI seca?
Hiperfluorescência por defeito em janela ou por acumulo da fluoresceína nos DEP drusenoides/staining das drusas.

Quais são os achados típicos das drusas no OCT?
Elevações da Linha do EPR, separando-a de outra linha hiperrefletiva: a Membrana de Bruch
Qual é o significado da Alterações Pigmentares, encontradas na DMRI?
Sofrimento do EPR.
Maior chance de progressão para formas avançadas.

O que é a Atrofia Geográfica?
área de atrofia de coriocapilar, EPR e fotorreceptores, maior que 175 micrômetros.

Quais são os achados típicos da Atrofia Geográfia da DMRI, na Autofluorescência?
Hipoautofluorescência na região de atrofia
Bordos hiperautofluorescêntes nas regiões onde ainda temos EPR viável, porém em sofrimento (EPR passa a acumular lifofucsina em situação de sofrimento pela perda da capacidade de metabolização dessas substâncias)

Qual é o achado característico da AGF da Atrofia Geográfica?
Hiperfluorescência por Defeito em Janela

Quais são os achados típicos do OCT da Atrofia Geográfica?
Perda da linha do EPR
Perda da Linha Elipsóide
Atrofia da Coriocapilar
Hipertransmissão da luz do aparelho, gerando sombra reversa.
Tubulações de Retina externa.

Quais são as condutas diante de um paciente com DMRI?
Mudança de dieta + atividade física para perda de peso
suspender o tabagismo
tratamento da HAS
Uso da Tela de Amsler para detecção precoce de alterações visuais.
Suplementação Vitamínica com AREDS
Qual é a Fórmula do AREDS 2?
Vitamina C 500mg
Vitamina E 400UI
Luteína 10mg
Zeaxantina 2mg
Zinco 80-25mg
Quais são os Estágios da DMRI, segundo o estudo AREDS?
Estagio I (sem DMRI):
Drusas pequenas
Estágio II (DMRI Inicial):
Muitas Drusas pequenas
OU
Presença de Drusas Intermediárias
Estágio III (DMRI Intermediária)
Presença de muitas drusas Intermediárias
OU
Presença de drusas grandes
OU
Atrofia geográfica não central
Estágio IV (DMRI Avançada)
Atrofia Geográfica Central
OU
DMRI Exsudativa
Qual é a fisiopatologia da DMRI Exsudativa ou DMRI Úmida?
EPR em sofrimento aumenta a produção de VEGF
O VEGF estimula o surgimento de neovasos a partir da coróide.
Esses Neovasos são incompetentes, extravasam parte de seu conteúdo, gerando DEPs, Líquido sub-retiniano, e sangramentos.
A presença concomitante de fibroblastos, pode levar a fibrose local, após regressão deses vasos, formando uma área extensa de fibrose sub-retiniana conhedida cono Cicatriz Disciforme.

Quais são achados típicos no exame fundoscópico que sugerem DMRI Exsudativa?
Extravasamento (exsudatos, edenma macular)
Hemorragias
Cicatriz disciforme

Qual é a classifcação da DMRI Exsudativa, de acordo com a AGF?
Oculta (87%):
Clássica (13%)

Como podemos classificas as MNV, de acordo com a sua localização?
Extrafoveal: > 200 micrômetros da fóvea
Justafoveal: <200 micrômetros da fóvea
Subfoveal: acomete o centro da mácula
Como podemos classificar as NVC através do OCT?
NVC Tipo I: abaixo do EPR
NVC Tipo II: entre a retina e o EPR
NVC Tipo III (Proliferação Angiomatosa da Retina)
Conecta o Plexo Capilar Profunda da retina com a coróide.
